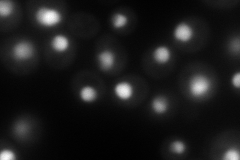
YML010W
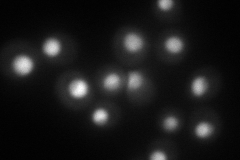
YML010W
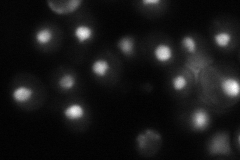
YML010W

View description
Protein involved in regulating Pol I and Pol II transcription and pre-mRNA processing; forms a complex with Spt4p; contains a C-terminal repeat domain that is a target for phosphorylation by Sgv1p
Localization:
Intensity:
Fold change:
Significance:
-
C’ GFP library in SD

nucleus87.17 -
N' NOP1pr-GFP in SD
nucleus,nucleolus150.676 -
N' TEF2pr-mCherry in SD
nucleus110.449 -
N' NATIVEpr-GFP in SD
nucleus65.5397 -
N' TEF2pr-VC and Cyto-VN in SD

nucleus52.239 -
C’ GFP library in SD+DTT

nucleus81.360.93No -
C’ GFP library in SD+H2O2

nucleus106.181.21No -
C’ GFP library in Starvation Media

nucleus81.230.93No -
C’ GFP library on the background of Pup2-DaMP

nucleus -
C’ GFP library on the background of CCT mutant

nucleus107.2021.22973No
